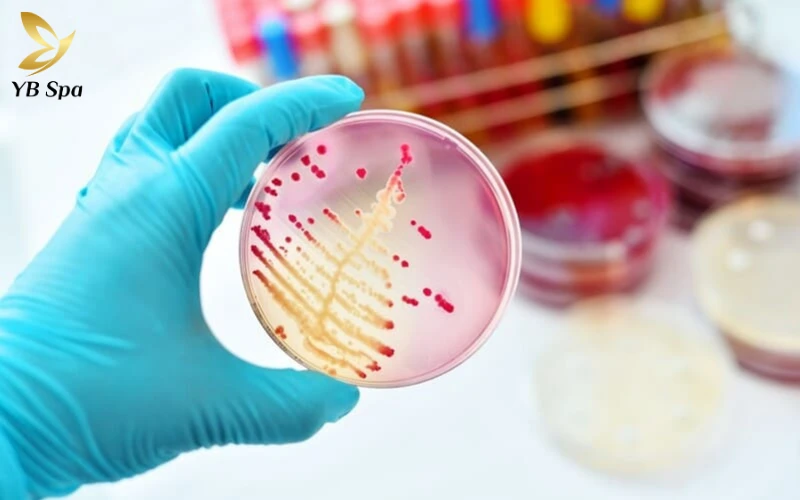
Vi khuẩn – nguyên nhân Gây Nổi Mụn Trong Mí Mắt Trên

Tóm tắt nhanh:
1. Thủ phạm gây mụn trong mí mắt
- Chắp và Lẹo: Đây là hai dạng phổ biến nhất. Lẹo thường do nhiễm khuẩn tụ cầu gây sưng đau, có mủ; trong khi Chắp do tắc nghẽn tuyến dầu (Meibomian) gây ra khối u cứng, ít đau hơn nhưng tồn tại lâu hơn.
- Viêm bờ mi: Do vệ sinh mắt kém, vi khuẩn hoặc ký sinh trùng tích tụ tại chân lông mi gây viêm và nổi mụn li ti.
- Dị ứng mỹ phẩm: Mascara, kẻ mắt hoặc kính áp tròng (lens) không vệ sinh có thể gây kích ứng niêm mạc, dẫn đến nổi mụn nước hoặc sưng đỏ.
- Virus Herpes: Nếu thấy mụn nước li ti mọc thành chùm, đau rát dữ dội, có thể bạn đã nhiễm virus và cần can thiệp y khoa ngay.
2. Cách xử lý an toàn và hiệu quả tại nhà
- Chườm ấm (Quan trọng nhất): Dùng khăn sạch thấm nước ấm (khoảng 40°C) đắp lên mắt 10-15 phút, 3-4 lần/ngày. Nhiệt độ ấm giúp làm giãn nở tuyến dầu bị tắc, giúp nhân mụn dễ thoát ra ngoài tự nhiên.
- Vệ sinh bằng nước muối sinh lý: Dùng tăm bông thấm nước muối sinh lý (NaCl 0.9%) nhẹ nhàng lau sạch bờ mi để loại bỏ vi khuẩn và vảy da chết.
- Tạm ngưng trang điểm và đeo lens: Tuyệt đối không dùng mỹ phẩm mắt hoặc kính áp tròng khi mắt đang viêm để tránh nhiễm trùng nặng hơn.
- Sử dụng túi trà ấm: Tannin trong trà xanh có tác dụng kháng viêm, giúp giảm sưng đau vùng mí mắt rất tốt.
Nổi mụn ở trong mí mắt trên là tình trạng khá phổ biến, có thể xảy ra ở mọi độ tuổi và giới tính. Dù những nốt mụn này thường nhỏ, nhưng lại gây cảm giác đau rát, cộm, sưng đỏ và khó chịu khi chớp mắt. Nhiều người chủ quan cho rằng đây chỉ là mụn thông thường, tuy nhiên trên thực tế, mụn ở mí mắt có thể liên quan đến viêm tuyến dầu, nhiễm khuẩn hoặc dị ứng, nếu không điều trị đúng cách có thể dẫn đến biến chứng ảnh hưởng thị lực. Trong bài viết này, YB Spa sẽ giúp bạn hiểu rõ nguyên nhân, dấu hiệu nhận biết và hướng điều trị an toàn – hiệu quả nhất để sớm lấy lại đôi mắt khỏe đẹp, dễ chịu.

Nguyên Nhân Gây Nổi Mụn Ở Trong Mí Mắt Trên
Vi khuẩn – nguyên nhân phổ biến nhất
Trong đa số trường hợp, tụ cầu vàng (Staphylococcus aureus) là “thủ phạm” chính. Đây là loại vi khuẩn thường trú trên da, đặc biệt quanh vùng mắt và mũi. Khi vi khuẩn này xâm nhập vào tuyến dầu hoặc nang lông ở mí mắt , chúng sẽ gây viêm, sưng đỏ và hình thành mụn mủ nhỏ .
Nếu không được điều trị đúng cách, vi khuẩn có thể lan rộng, dẫn đến tình trạng mụn lẹo hoặc áp xe mí mắt .
Virus – đặc biệt là Herpes simplex
Một số virus, đặc biệt là Herpes simplex , có thể gây ra mụn nước nhỏ, đau rát quanh vùng mắt , kèm cảm giác nóng, sưng và châm chích. Dạng mụn này dễ tái phát khi hệ miễn dịch suy yếu hoặc cơ thể bị căng thẳng kéo dài.
Nấm – nguyên nhân hiếm nhưng nguy hiểm
Mặc dù ít gặp hơn, nhiễm nấm vùng mắt (thường do Candida hoặc Aspergillus ) vẫn có thể xảy ra, đặc biệt ở người có cơ địa da dầu, ra mồ hôi nhiều hoặc dùng kháng sinh kéo dài. Biểu hiện thường là mí mắt ngứa, bong tróc nhẹ, nổi mụn nhỏ li ti kèm vảy da .
Tắc Nghẽn Tuyến Dầu (Tuyến Meibomian)
Tuyến Meibomian là những tuyến nhỏ nằm dọc bờ mí, có nhiệm vụ tiết ra lớp dầu mỏng để ngăn bay hơi nước mắt và bảo vệ giác mạc . Khi tuyến này bị tắc nghẽn , dầu không thoát ra được sẽ tích tụ lại, tạo thành mụn chắp hoặc u nang nhỏ nằm trong mí mắt trên.

Dị ứng mỹ phẩm
Nhiều trường hợp mụn trong mí mắt xuất phát từ phản ứng dị ứng với mỹ phẩm , đặc biệt là các sản phẩm chứa hương liệu, cồn, hoặc kim loại nặng như mascara, eyeliner, kem dưỡng mắt, phấn mắt,…
Dung dịch kính áp tròng và thuốc nhỏ mắt
Người sử dụng lens (kính áp tròng) thường xuyên hoặc thuốc nhỏ mắt chứa corticoid, chất bảo quản có thể gặp tình trạng viêm mí nhẹ , dẫn đến sưng đỏ và nổi mụn nhỏ quanh vùng bờ mi.
Thói quen chạm tay lên mắt
Thói quen chạm tay lên mắt tưởng chừng vô hại nhưng lại tạo điều kiện cho vi khuẩn từ tay xâm nhập và phát triển trên vùng da mí mỏng manh, dễ gây viêm nhiễm, nổi mụn hoặc kích ứng mắt.

Dấu Hiệu Nhận Biết Mụn Trong Mí Mắt Trên
Việc phân biệt mụn mí mắt với mụn lẹo, chắp hoặc viêm bờ mi rất quan trọng để điều trị đúng hướng.
1. Triệu Chứng Thường Gặp
- Cảm giác đau nhói, rát hoặc cộm khi chớp mắt
- Mí mắt sưng đỏ, có nốt gồ nhỏ bên trong hoặc sát bờ mi
- Cảm giác ngứa, khó chịu, chảy nước mắt nhiều hơn bình thường
- Khó mở mắt buổi sáng, mí có thể dính nhẹ
- Nhạy cảm ánh sáng, sợ chói khi ra nắng
- Nhìn mờ tạm thời nếu mụn sưng lớn
Những dấu hiệu này thường khiến người bệnh nhầm lẫn với mụn lẹo (viêm nang lông mi có mủ) hoặc mụn chắp (u tuyến dầu không nhiễm trùng). Tuy nhiên, chỉ bác sĩ nhãn khoa mới có thể xác định chính xác dạng mụn bạn đang gặp phải.

2. Biến Chứng Nếu Không Điều Trị Kịp Thời
Việc chủ quan, tự nặn hoặc dùng thuốc bừa bãi có thể dẫn đến nhiều hệ quả nguy hiểm:
- Viêm lan rộng sang giác mạc, kết mạc hoặc mô xung quanh mắt
- Mụn chuyển thành chắp mạn tính, hình thành khối u cứng khó tan
- Tổn thương bờ mi, gây rụng lông mi hoặc để lại sẹo
- Nặng hơn, có thể gây áp xe mí mắt hoặc ảnh hưởng thị lực tạm thời
Cách Điều Trị Mụn Trong Mí Mắt Bằng Thuốc (Theo Chỉ Định Của Bác Sĩ)
| Loại Thuốc | Công Dụng Chính |
| Thuốc mỡ kháng sinh tại chỗ | Giúp tiêu viêm, diệt khuẩn, giảm sưng đỏ. Thường được bôi trực tiếp lên vùng mí có mụn. |
| Thuốc nhỏ mắt kháng viêm | Làm dịu cảm giác đau rát, giảm sưng và ngăn ngừa lan rộng vi khuẩn. |
| Thuốc giảm đau, hạ sốt | Dành cho trường hợp sưng viêm nặng, giúp giảm đau, giảm khó chịu. |
| Thuốc chống dị ứng | Hiệu quả trong các trường hợp mụn do kích ứng mỹ phẩm hoặc môi trường. |
Lưu ý: Việc sử dụng thuốc cần có chỉ định từ bác sĩ chuyên khoa mắt hoặc da liễu . Tự ý dùng thuốc, đặc biệt là thuốc chứa corticoid , có thể gây khô mắt, mỏng da mí hoặc tổn thương giác mạc.
Cách Điều Trị Tại Nhà Giúp Giảm Mụn Trong Mí Mắt Trên
Bên cạnh điều trị bằng thuốc theo chỉ định bác sĩ, người bệnh hoàn toàn có thể hỗ trợ cải thiện tình trạng mụn mí mắt tại nhà bằng các phương pháp an toàn, lành tính. Những cách này không chỉ giúp giảm sưng đau nhanh hơn mà còn ngăn ngừa tái phát hiệu quả.
1. Chườm Ấm – Giúp Thông Tuyến Dầu Và Giảm Viêm
- Dùng khăn bông sạch thấm nước ấm khoảng 40–45°C, vắt nhẹ và đắp lên mí mắt trong 10–15 phút.
- Thực hiện 3–4 lần mỗi ngày để giúp làm mềm tuyến dầu, tăng lưu thông tuần hoàn quanh mắt và hỗ trợ mụn nhanh khô.
Lưu ý: Không dùng nước quá nóng vì có thể gây bỏng da mỏng ở mí mắt.

2. Giữ Vệ Sinh Vùng Mắt Hằng Ngày
- Rửa tay sạch trước khi chạm vào mắt hoặc thoa thuốc.
- Tẩy trang kỹ vùng mí , đặc biệt nếu bạn thường xuyên trang điểm.
- Dùng bông tẩy trang mềm, không cồn , hoặc dung dịch vệ sinh mắt chuyên dụng.
- Hạn chế dụi mắt , dùng chung khăn mặt hoặc gối nằm bẩn , vì đây là môi trường lý tưởng cho vi khuẩn sinh sôi.
3. Dùng Túi Trà Ấm Giảm Viêm Tự Nhiên
Trà xanh hoặc trà đen chứa tannin và polyphenol – hoạt chất có khả năng kháng viêm và làm dịu sưng đau tự nhiên . Cách thực hiện:
- Ngâm túi trà trong nước nóng 3–5 phút, để nguội bớt.
- Đắp lên mí mắt ấm trong 10 phút, ngày 1–2 lần.
Phương pháp này giúp giảm viêm nhẹ và thư giãn vùng mắt, nhất là sau khi làm việc lâu trước màn hình.
4. Không Đeo Lens Khi Đang Bị Mụn
Việc tiếp tục dùng mascara, phấn mắt hoặc kính áp tròng khi mí mắt đang sưng viêm có thể khiến tình trạng trở nên nghiêm trọng hơn.
Hóa chất trong mỹ phẩm và ma sát từ lens dễ làm tắc nghẽn tuyến dầu hoặc gây kích ứng thứ phát .
Tốt nhất, nên ngưng sử dụng hoàn toàn cho đến khi mụn khỏi hẳn .

5. Duy Trì Chế Độ Sinh Hoạt Khoa Học
Một giấc ngủ đủ giấc, chế độ ăn uống cân bằng và thói quen sinh hoạt lành mạnh giúp tăng sức đề kháng da, hạn chế mụn tái phát:
- Ngủ đủ 7–8 tiếng mỗi đêm để cơ thể phục hồi và tái tạo da.
- Uống 2–2.5 lít nước mỗi ngày giúp thanh lọc độc tố.
- Ăn nhiều rau xanh, trái cây, thực phẩm giàu vitamin A, C, E (cà rốt, bông cải xanh, cam, chanh…) để da khỏe và giảm viêm.
- Hạn chế đồ ăn cay nóng, chiên rán, nước ngọt có gas, rượu bia .
Khi Nào Cần Đến Gặp Bác Sĩ?
Mặc dù phần lớn các trường hợp mụn mí mắt có thể tự khỏi trong vài ngày đến một tuần, nhưng bạn nên đến bác sĩ nhãn khoa hoặc da liễu ngay nếu có các dấu hiệu sau:
- Mụn sưng to, đau nhiều hoặc mưng mủ.
- Mí mắt phù nề, đỏ lan rộng xuống vùng má hoặc quanh mắt.
- Mụn tái phát thường xuyên, kéo dài trên 2 tuần không cải thiện.
- Cảm giác nhìn mờ, chói sáng hoặc đau khi cử động mắt.
- Có dịch vàng hoặc mủ chảy ra, kèm sốt nhẹ.

Mụn trong mí mắt trên là tình trạng tuy nhỏ nhưng có thể gây khó chịu và tiềm ẩn nguy cơ biến chứng nếu không điều trị đúng cách. Việc xác định nguyên nhân – từ vi khuẩn, tắc tuyến dầu đến yếu tố lối sống – là chìa khóa quan trọng giúp điều trị dứt điểm và phòng ngừa tái phát.
Nếu bạn đang gặp tình trạng này, hãy:
- Giữ vệ sinh vùng mắt cẩn thận ,
- Không tự ý nặn hoặc dùng thuốc bừa bãi ,
- Thăm khám bác sĩ chuyên khoa khi có dấu hiệu sưng đau kéo dài.
Hy vọng rằng bài viết “Nổi Mụn Ở Trong Mí Mắt Trên: Nguyên Nhân Và Cách Điều Trị Hiệu Quả” đã giúp bạn hiểu rõ hơn về tình trạng này và tìm ra giải pháp phù hợp để đôi mắt luôn sáng khỏe, tự tin mỗi ngày.
Có thể bạn quan tâm:
- Cách trị mụn thịt quanh mắt an toàn và hiệu quả tại nhà
- Nguyên nhân mí mắt nổi mụn nước là gì? Có nguy hiểm không?
- Công thức trị mụn bằng nha đam tại nhà lành tính hiệu quả cao
- Cách Trị Mụn Đầu Đen Trên Trán Tại Nhà An Toàn Và Hiệu Quả
- Mụn thịt dư là gì? Mụn thịt dư có gây ra biến chứng gì không?
Đặt lịch ngay tại Viện Thẩm Mỹ YB Spa để được soi da, thăm khám và tư vấn liệu trình phù hợp hoàn toàn miễn phí.
📞 Hotline tư vấn & đặt lịch: 0764.208.777

